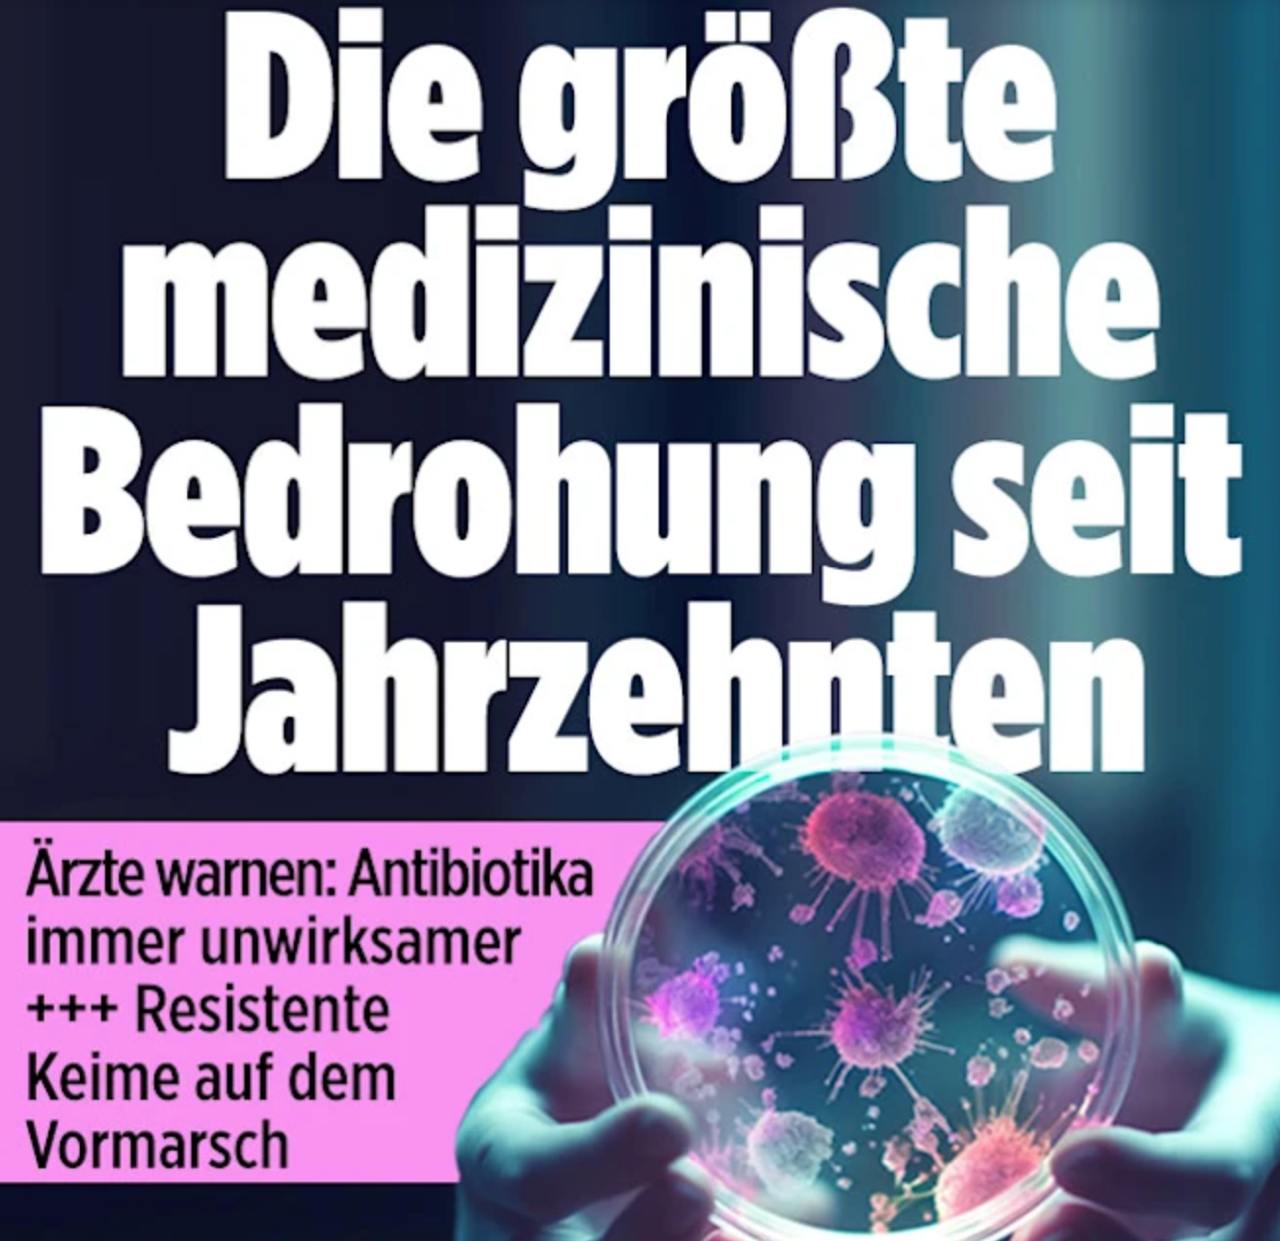

Антибиотики перестают работать, учёные бьют тревогу из-за крупнейшей медицинской угрозы - Bild
Антибиотики перестают работать, учёные бьют тревогу из-за крупнейшей медицинской угрозы последних десятилетий.
Об этом пишет Bild.
Открытие пенициллина в прошлом веке привело к резкому росту продолжительности жизни человека.
"Благодаря первому антибиотику люди могут жить на 30 лет дольше по сравнению с временами до его появления. Сейчас человечество рискует вновь проиграть эту борьбу. Всё больше бактерий становятся устойчивыми к антибиотикам, а новых препаратов крайне мало", - говорится в статье.
Недавнее исследование показало, что к 2050 году от инфекций, вызванных антибиотикорезистентными микроорганизмами, могут умереть более 39 млн человек по всему миру. Уже сейчас в одном лишь Европейском союзе ежегодно погибают 35 000 человек от инфекций, вызванных устойчивыми патогенами.
"Во-первых, в амбулаторной практике всё ещё слишком часто назначают антибиотики. Во-вторых, с восстановлением международных поездок после пандемии к нам поступает множество резистентных бактерий. Особенно высокие уровни устойчивости наблюдаются в таких странах, как Греция, Португалия, Турция, а также Индия и другие страны Азии. Людей нужно предупреждать: если кто-то привезёт из отпуска такую бактерию и заразит ею, например, своего больного дедушку, это может стать для него смертельным", - рассказал профессор интенсивной терапии Франк М. Брункхорст (университетская клиника Йены).
Во многих случаях приём антибиотиков не нужен, подчёркивают специалисты. Например, почти при всех инфекциях дыхательных путей. Также антибиотики слишком легко назначают при инфекциях мочевых путей, таких как цистит, хотя в большинстве случаев это не требуется.
Также нехватка новых антибиотиков усугубляет кризис. С 2017 года было одобрено всего 12 новых антибиотиков.
Напомним, что при бесконтрольном и неправильном приеме антибиотиков может развиться антибиотикорезистентность – приобретение бактериями стойкости к лечению.




